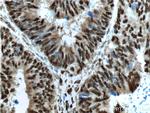
OCT1 Antibody in Immunohistochemistry (Paraffin) (IHC (P))

Search
Proteintech
OCT1 Polyclonal Antibody
{{$productOrderCtrl.translations['antibody.pdp.commerceCard.promotion.promotions']}}
{{$productOrderCtrl.translations['antibody.pdp.commerceCard.promotion.viewpromo']}}
{{$productOrderCtrl.translations['antibody.pdp.commerceCard.promotion.promocode']}}: {{promo.promoCode}} {{promo.promoTitle}} {{promo.promoDescription}}. {{$productOrderCtrl.translations['antibody.pdp.commerceCard.promotion.learnmore']}}
产品信息
10387-1-AP
种属反应
已发表种属
宿主/亚型
分类
类型
抗原
偶联物
形式
浓度
规格
纯化类型
保存液
内含物
保存条件
运输条件
产品详细信息
Immunogen sequence: RRKKRTSIE TNIRVALEKS FLENQKPTSE EITMIADQLN MEKEVIRVWF CNRRQKEKRI NPPSSGGTSS SPIKAIFPSP TSLVATTPSL VTSSAATTLT VSPVLPLTSA AVTNLSVTGT SDTTSNNTAT VISTAPPASS AVTSPSLSPS PSASASTSEA SSASETSTTQ TTSTPLSSPL GTSQVMVTAS GLQTAAAAAL QGAAQLPANA SLAAMAAAAG LNPSLMAPSQ FAAGGALLSL NPGTLSGALS PALMSNSTLA TIQALASGGS LPITSLDATG NL (379-659 aa encoded by BC003571)
靶标信息
OCT1 (POU2F1) is a ubiquitously expressed transcription factor that binds to the octamer motif (5'-ATTTGCAT-3') and activates the promoters of the genes for some small nuclear RNAs (snRNA) and of genes such as those for histone H2B and immunoglobulins. It modulates transcription transactivation by NR3C1, AR and PGR. In case of human herpes simplex virus (HSV) infection, POU2F1 forms a multiprotein-DNA complex with the viral transactivator protein VP16 and HCFC1 thereby enabling the transcription of the viral immediate early genes.
仅用于科研。不用于诊断过程。未经明确授权不得转售。
生物信息学
蛋白别名: lymphocyte-specific isoform; NF-A1; Oct-1; octamer binding protein 1; Octamer-binding protein 1; Octamer-binding transcription factor 1; Octamer-binding transcription factor-1; OTF-1; POU domain, class 2, transcription factor 1; POU homeodomain protein; unnamed protein product
基因别名: oct-1B; OCT1; Oct1Z; OTF1; POU2F1
UniProt ID: (Human) P14859, (Pig) Q29076
Entrez Gene ID: (Human) 5451, (Pig) 397501